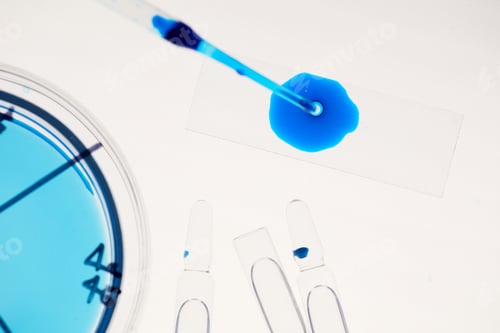
Preview: Specimen And Ampoules Flat Lay
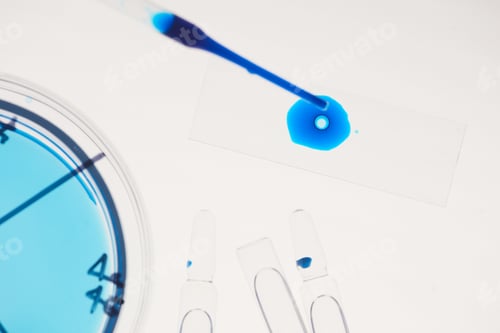
Preview: Examining of samples in the lab

Blot Royalty-Free Stock Photos
Browse our library and you will find many awesome royalty-free blot stock photos, pictures and images. We are confident you will find the right one for your project!
How satisfied are you with your Photos experience today?